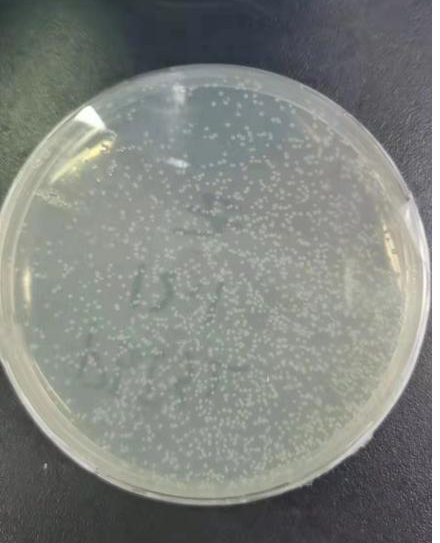

PCR(polymerase chain reaction)擴增目的片段→電泳(electrophoresis)→純化(purification)→連接 (ligase )→轉化(transformation)→陽性克隆(positive clone)→檢測(detection)

圖1:無縫克隆流程圖(圖片來源于網絡)
2. PCR擴增:選擇要擴增的目的片段,在正義鏈和反義鏈的末端分別設計一條帶有線性化載體正義鏈和反義鏈部分同源序列一致的引物,此處參考說明書建議(15-25bp)。為了減少非特異性擴增,建議與靶序列的匹配度越高越好。
3.電泳:PCR結果的好壞通常通過瓊脂糖凝膠電泳來觀察條帶有無或者濃度大小,基本原理是瓊脂糖凝膠介質中添加了在紫外下可以顯色的EB, 這種試劑可以嵌合到核酸分子中,與DNA雙鏈結合,因此,分子量越大的DNA分子,顯色度越高,在相同濃度下也越亮。有的時候如果分子量很小的DNA, 濃度又不高的情況下,DNA條帶有可能會出現假陰性的結果。
4.目的片段的純化(膠回收):PCR擴增結束后,體系中可能會有未參與反應的聚合酶,Mg2+等,所以一般是建議通過純化的步驟將這些雜質去除,以利于后續反應的穩定進行。
載體線性化:目的片段插入需要將環狀的質粒用酶來消化成線性的雙鏈DNA分子,實際情況下載體消化會因為反應時間和酶量多少而有較大區別,如果用于后續的基因克隆,建議消化盡量完全。
5.連接反應:Biomarker MultiF Seamless Assembly Mix試劑盒可以將多個片段組合到載體上,形成一個環狀的重組質粒。用于后續的建庫測序或者誘導蛋白表達。
6.轉化:基本原理是質粒容易在大腸桿菌中穩定繁殖,這部分是基因克隆的關鍵,如果成功,后續的平板上會有單克隆的出現。有單克隆出現可以進行下一步實驗。單克隆平板可以在4 ℃冰箱存放一個月,仍然不失效。
7.檢測:挑取帶有抗生素平板單克隆擴大培養,3-4 h, 使質粒拷貝數增加,隨后用于菌落PCR檢測,是否是插入了目標片段的質粒。
小貼士
其他判斷陽性單克隆的方法?
最可靠的方法是酶切,一個環狀重組質粒,在對應的位置用限制性內切酶雙酶切后,會出現兩個目的片段,如果不能出現兩個片段,一般可以認為是空載體沒有線性消化完全。
結果展示

圖2:單克隆檢測示意圖
結果分析
攜帶有目的片段的質粒能夠抵抗抗生素,才使得在平板培養基上長出來。但也有可能是沒有消化完全的空質粒。因此,下一步的鑒定實驗顯得尤為重要。菌落PCR在分子生物學實驗中,容易有假陽性出現,可能的原因很多,因此,最根本的方法就是提高陽性率。以質粒為模板擴增,產物濃度會很高,可作為判定假陽性的一個依據。以及上述所提及的質粒的酶切,都是最常用的方法。
保存條件
產品應用
DNA定點突變
相關產品

京公網安備 11011302003368號